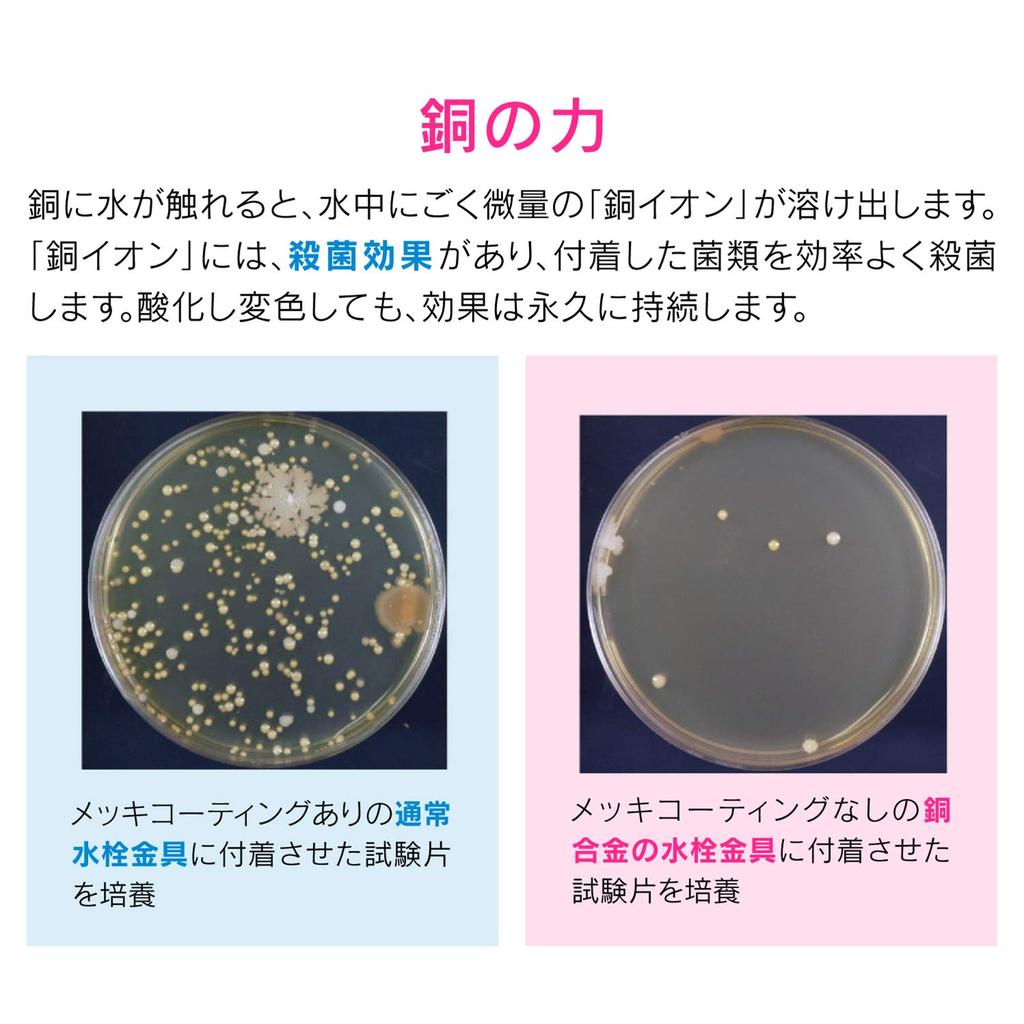
Gaona Kore Eeyan GA-RA003 Retro Versatile Garden Faucet

The website doesn't support your browser. Please update your browser or download a different one
Gaona Kore Eeyan GA-RA003 Retro Versatile Garden Faucet
Current price
Price €84.49
Free delivery 16 November - 16 December
Returns & refunds
Secure payments



Our support team speaks English
Description
Gaona Kore Eeyan GA-RA003 Retro Versatile Garden Faucet — buy online with free worldwide shipping!
Available colours:
High-quality materials:
High-quality photos and real customers reviews.
Wide size range: